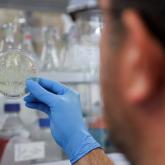

26/11/2021

Actualidad
España restringirá tráfico aéreo con Sudáfrica y Botsuana por nueva variante
España aprobará el próximo martes en Consejo de Ministros un acuerdo para la restricción de vuelos procedentes
26/11/2021

Actualidad
España aprobará el próximo martes en Consejo de Ministros un acuerdo para la restricción de vuelos procedentes
25/11/2021

Mundo
Los científicos apuntan a que la variante B.1.1.529 de la covid-19 puede hacer que "las vacunas que actualmente
13/7/2021

Actualidad
Se trata de una mujer de 40 años, cuya familia está dentro del cerco epidemiológico a fin de poder verificar
28/4/2021

Mundo
Es el cuarto país con más muertes registradas desde el inicio de la pandemia, solo por detrás de Estados
25/4/2021

Actualidad
El reporte fue enviado al Ministerio de Salud por el Instituto de Microbiología de la Universidas San
12/4/2021

Ciencia y Tecnología
Dos nuevos estudios no hallaron evidencias de que personas con esta variante experimentaran peores
22/3/2021
Mundo
Los efectos de la nueva variante aún se desconocen, según informó este lunes el diario belga Le Soir
18/2/2021

Actualidad
El organismo informó que los indicios señalan que la mutación no causa síntomas graves